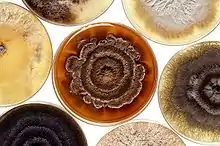
Cultures of the destructive mold called Phomopsis

| Phomopsis | |
|---|---|
![]() | |
| Cultures of the destructive mold called Phomopsis | |
| Scientific classification | |
| Domain: | Eukaryota |
| Kingdom: | Fungi |
| Division: | Ascomycota |
| Class: | Sordariomycetes |
| Order: | Diaporthales |
| Family: | Valsaceae |
| Genus: | Phomopsis Sacc. & Roum.[1] |
| Species[2] | |
| |
Phomopsis is a genus of ascomycete fungi in the family Diaporthaceae. It was previously in the Valsaceae family.[2]
Species
680 records are listed by Species Fungorum;[4]
See List of Phomopsis species (for full list of species).
Selected species list includes;
- Phomopsis arnoldiae
- Phomopsis asparagi
- Phomopsis asparagicola
- Phomopsis azadirachtae
- Phomopsis cannabina
- Phomopsis caricae-papayae
- Phomopsis coffeae
- Phomopsis durionis Syd. 1932[3]
- Phomopsis elaeagni
- Phomopsis ganjae
- Phomopsis javanica
- Phomopsis juniperovora
- Phomopsis lokoyae
- Phomopsis longicolla
- Phomopsis mangiferae
- Phomopsis obscurans
- Phomopsis perseae
- Phomopsis pittospori
- Phomopsis prunorum
- Phomopsis sojae
- Phomopsis scabra
- Phomopsis sclerotioides
- Phomopsis tanakae
- Phomopsis theae
- Phomopsis viticola
Formerly placed here:
- Phomopsis vaccinii, now Diaporthe vaccinii[4]
- Phomopsis leptostromiformis, now Diaporthe toxica[4]
Dead-arm infection
One of the species of this genus, P. viticola, cause a grape disease called Phomopsis or dead-arm. Usually, infections begin during early growth stages in spring. This affects leaves, fruit, rachises, and shoots of a plant.
This disease causes the formation of lesions on shoots, leaves, and rachises, but also can cause fruit rot.
It causes significant economic damage to grape vines.
Another Phomopsis species, P. juniperovora, infects junipers, and is a particularly important pest of seedlings and juvenile plants in the nursery industry.
See also
References
- ↑ Saccardo, P.A.; Roumeguère, C. 1884. Reliquiae mycologicae Libertianae. IV. Revue Mycologique Toulouse. 6:26-39
- 1 2 "Phomopsis". NCBI taxonomy. Bethesda, MD: National Center for Biotechnology Information. Retrieved 27 June 2018.
- 1 2 Sydow, Hans 1932. Novae fungorum species - XXI. Annales Mycologici. 30:91-117
- 1 2 3 "Phomopsis - Search Page". www.speciesfungorum.org. Species Fungorum. Retrieved 18 April 2023.
External links
- http://winegrapes.tamu.edu/grow/diseases/phomopsis.shtml
- http://na.fs.fed.us/spfo/pubs/fidls/phomopsis/phomopsis.htm